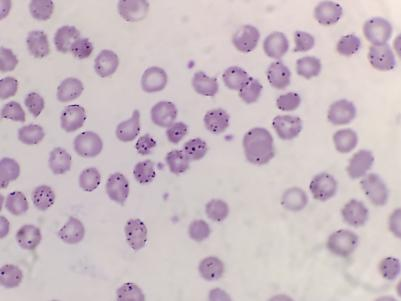
202512011558091243.png
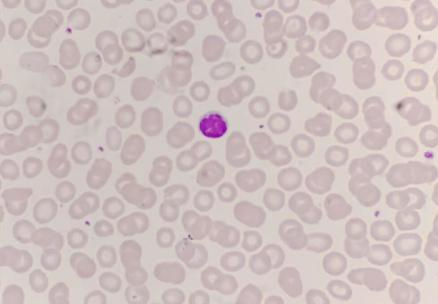
202512011559002434.png

蹊跷的病例:腹痛患者,线索指向“中毒”
某男性腹痛患者初步检查后结果令人困惑:血常规显示中度贫血(HGB75g/L,男性正常参考值130~175g/L),但体内的“造血工厂”——骨髓,却异常活跃(网织红细胞计数显著升高8.78%,正常参考值0.3%~3%)。外周血涂片看到了一个关键的、不寻常的线索:大量嗜碱性点彩红细胞。这个发现高度怀疑是重金属中毒。建议患者相关检测,结果显示血铅715.0ug/l;(成人正常参考值<100ug/l),患者血铅结果高出正常人数倍,印证了铅中毒的推断。
图1.患者血片含大量嗜碱性点彩红细胞

图2.患者血片含大量嗜碱性点彩红细胞
图3.正常血片(不含嗜碱性点彩红细胞)
科普小课堂
(一)什么是嗜碱性点彩红细胞?
嗜碱性点彩红细胞是一种尚未成熟的红细胞,在发育过程中受到损害,如某些重金属(铅、铋、汞),其中胞质中残存的嗜碱性物质(RNA)变性沉淀而形成。经特殊染色(瑞氏染色)后,可见红细胞粉红色胞质中呈现出粗细不等的蓝黑色颗粒,如同“灿烂星空”。这是重金属中毒的一个典型特征。区别正常情况下,红细胞在显微镜下是均匀的淡红色。
(二)生活中铅常见隐藏地点
1.化妆品:某些廉价或“三无”产品为追求显色度和效果,可能铅超标。尤其是口红、染发剂、美白祛斑产品。
2.儿童玩具/文具:劣质油漆、彩色颜料。
3.劣质的传统工艺品:色彩鲜艳的彩釉陶瓷、锡壶。
4.劣质图书:部分盗版书的铅含量比同类正版书籍高出很多倍。
5.工业污染:汽车尾气、工业废气、老式水管、含铅油漆、受污染的土壤等。
6.烟,二手烟。
7.高铅食品:高铅食品,如松花蛋、老式转炉爆米花、铁皮罐头、近海海产品等。
8.家庭装修:木器涂料、彩色壁纸等(劣质材料含铅量高)。
(三)铅的危害
1.神经系统损害:对中枢和外周神经系统有严重影响,可能导致智力下降、行为变化、注意力不集中等。
2.成人健康:高血压、心血管问题、肾脏损伤等。
3.生殖系统影响:可影响生殖能力,导致不孕、流产及畸胎等。
(四)典型临床症状
1.神经系统:全身无力、四肢麻木、攻击性行为;头痛、记忆力下降、失眠、手抖等症状;
2.消化系统:口内金属味、恶心、腹胀、便秘或腹泻、便血、腹部绞痛(阵发性脐周绞痛)等症状;
3.血液系统:贫血,表现为面色苍白、乏力、心累气促等症状。
4.儿童表现:智力下降、多动、注意力下降、厌食等症状。
5.其他:肾功能异常,牙龈可能出现“铅线”。
(五)如何预防
严把入口关:避免或减少食用含铅量高的食品,爆米花,松花蛋。多吃富含钙、铁、锌的食物,如牛奶、鸡蛋、瘦肉、绿蔬菜等,可以帮助拮抗铅的吸收。选择无铅餐具,彩釉餐具别放热食/酸食,高温加速铅的析出。
警惕“毒源关”:书籍、玩具、化妆品等也要购买合格产品:雾化器选择无铅雾化。家里装修时选用环保材料,避开污染环境。
养成卫生习惯:勤洗手减少手-口转移,居家常开窗通风,保持室内清洁。
定期筛查:早发现,早干预,是防范铅超标的重要手段。
(六)治疗与急救原则
立即脱离毒源:停止使用可疑物品,离开污染环境。
就医:人体自身难以有效排出大量铅元素,自然恢复的可能性微乎其微应第一时间前往职业病防治院或大型医院中毒科就诊。
驱排治疗:医生会使用金属螯合剂(如EDTA、二巯丙醇等),这些药物能像“磁铁”一样,与血液中的重金属结合,通过尿液排出体外。此治疗必须严格在医生监控下进行!
重金属中毒这个看似遥远的“工业病”,其实就潜伏在我们的日常生活中。提高警惕,做自己健康的“第一责任人”,才能让这些隐形杀手无处遁形。


